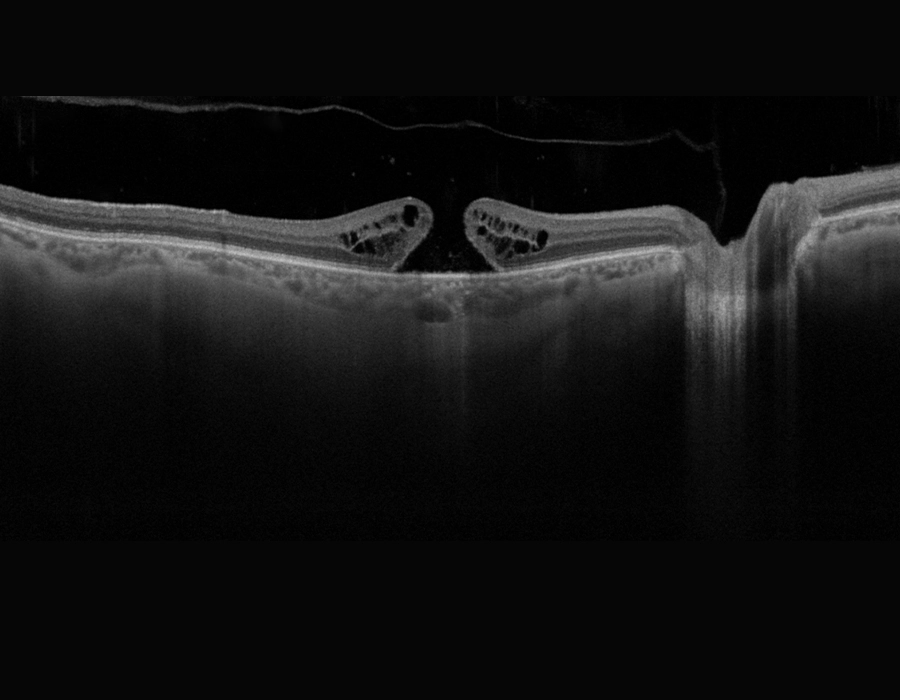
OCT RE full thickness macular hole
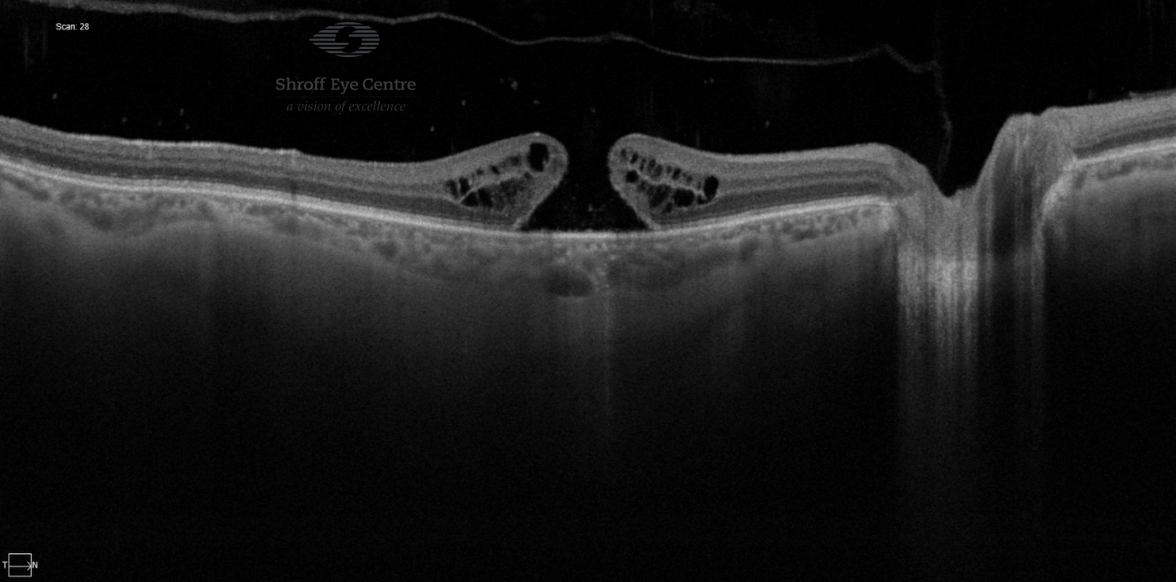
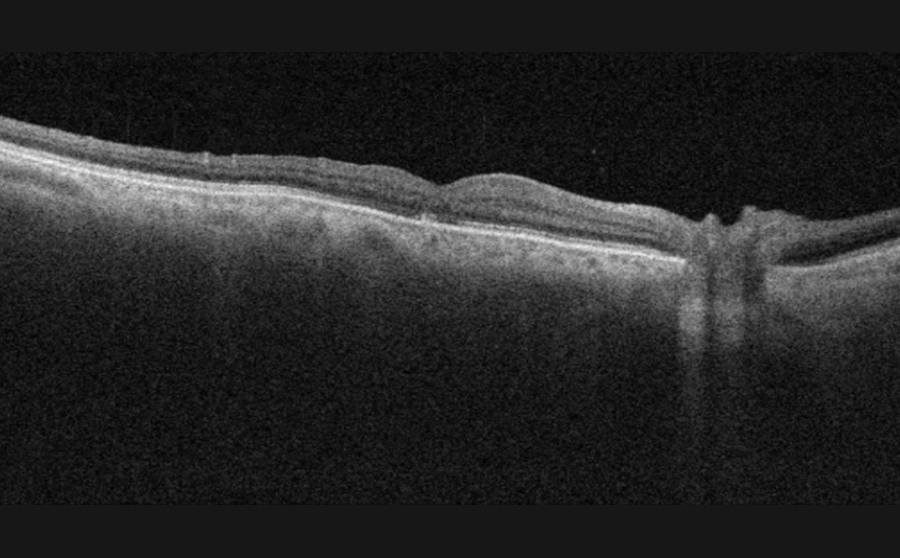
OCT macular hole after vitroretina surgery

As a family from Dehradun, we had the privilege of experiencing exceptional care at Shroff Eye Centre ,Kailash colony ,Delhi for my 69-year-old mother's advanced Vitreo-Retinal(macular hole) surgery.
I'm overwhelmed with gratitude for the outstanding treatment she received.
Dr. Darius's expertise shines through in every aspect of his work, and his impressive qualifications, including being a Fellow of the Royal College of Surgeons, highlight his commitment to upholding the highest standards in surgery.
From the moment we stepped into the centre, the staff's professionalism and kindness impressed us. The liftman, nurses, reception counselors, and anesthetists were all courteous and efficient.
Dr. Darius's skill, experience, and compassion gave us immense confidence throughout the surgery process. His team worked seamlessly together to ensure my mother's comfort and safety.
The centre's integrated computer system is also noteworthy, ensuring that all patient information is readily available and no detail is missed. This level of organisation and optimal use of technology clearly contributes to the high standard of care provided.
Although we had to travel far for the surgery, it was worth every bit.
I wholeheartedly recommend Shroff Eye Centre and Dr. Darius to anyone seeking world-class eye treatment.
Their commitment to delivering exceptional patient care is truly commendable."
I give : 5/5 stars to Shroff eye centre
Your Eyes, Our Passion
Macular Hole- Symptoms, Diagnosis & Surgery in Delhi NCR at Shroff Eye Centre
Overview
A macular hole is a defect in the macula which is the central part of your retina. This can cause difficulty in seeing properly, especially problems with your central vision. Surgery is usually needed to repair the hole.
Content
What is a macular hole?
A macular hole is an opening or hole in the center of the retina (macula). The Macula is an important structure in the eye located on your retina- or the back of your eye. The retina has lots of nerve cells which react to light and allow us to see. These nerves are very densely packed in the macula and are responsible for our central vision. Central vision allows you to see the details or fine vision while we are looking straight ahead and helps us in tasks like reading, writing and recognizing faces.
Symptoms & Causes
What causes a macular hole?
Scientists and doctors don’t fully understand why macular holes develop. In most cases there is no obvious cause.
Usually it's seen because of age related changes in the gel-like structure (vitreous) inside your eye. Normally, the vitreous is attached to the surface of the retina. As we age, the vitreous gel may shrink and separate from the retina. A macular hole occurs when while separating, the vitreous gel pulls on the macula due to abnormal firm attachment.
Some cases may be associated with
- Retinal detachment
- severe injury or trauma to the eye
- being very short-sighted (high myopia)
- persistent swelling of the central retina (cystoid macular oedema)
- Diabetic retinopathy
- Hypertensive retinopathy
What are the risk factors for developing a macular hole?
Age above 60 is the most important risk factor
Other less common risk factors include:
- Women are affected more commonly than men
- Previous eye injury
- History of other retina problems or inflammatory conditions of the eye
- Being a high myope
- If you have a macular hole in one eye, the risk of developing a macular hole in the other eyes is higher.
What are the symptoms of macular hole?
Symptoms of a macular hole may include
- Difficulty in seeing features on people’s faces distinctly
- Difficulty in reading or driving
- Blurred or distorted central vision (straight lines might appear curvy)
- As the macular hole gets larger, you may see a large dark spot in your central vision.
The severity of the symptoms depends on the size of the macular hole. Your peripheral vision remains unaffected even if the hole is large or long-standing.
Diagnosis and Tests
How is a macular hole diagnosed?
Your retina specialist will ask about your medical history and any medication you’re on. To diagnose a macular hole, a dilated eye examination is required. Your eye power (refraction), slit-lamp examination and retina examination is done.
Dilating drops are put in your eyes to widen the pupil- this helps in examining your retina.
Which tests are done to detect a macular hole?
Macular holes are seen on indirect ophthalmoscopy once the retina is dilated. Retina specialists may also ask for
- OCT (optical coherence tomography) is a non-invasive scan of the retina which confirms the diagnosis. OCT takes cross-sectional images of the retinal layers and helps in ruling out other similar-looking diseases of the eye. It also helps to pick up any early changes in the fellow eye.
- Fluorescein Angiography: A dye is used to visualise and evaluate blood flow to identify any underlying retinal issues contributing to the macular hole.
How is macular hole classified?
Retina specialists use two main ways of classifying macular holes.
Gass first described his clinical observations on the evolution of a macular hole (MH) as follows (2)
- Stage 1 (impending MH): Loss of foveal depression.
- Stage 1A: Foveolar detachment with loss of contour and a lipofuscin-colored spot.
- Stage 1B: Foveal detachment with a lipofuscin-colored ring.
- Stage 2: Full-thickness break < 400 µm. in size in the fovea.
- Stage 3: Full-thickness foveal defect ≥ 400 µm; in size. A grayish macular rim often denotes a cuff of subretinal fluid. Usually, PVD is started in this stage with or without an operculum.
- Stage 4: Stage 3 MH with a complete posterior vitreous detachment (PVD) and a Weiss ring.
In 2013, the International Vitreomacular Traction Study Group also formed a classification scheme of vitreomacular traction and macular holes based on OCT findings (1,3)
- Vitreomacular adhesion: No distortion of the foveal contour; size of attachment area between hyaloid and retina defined as focal if ≤1500 microns and broad if >1500 microns
- Vitreomacular traction (VMT): Distortion of foveal contour present or there are intraretinal structural changes in the absence of a full-thickness MH; size of attachment area between hyaloid and retina defined as focal if ≤1500 microns and broad if >1500 microns
- Full-thickness macular hole (FTMH): Full-thickness defect from the internal limiting membrane (ILM) to the retinal pigment epithelium. Size is based on the horizontal diameter at the narrowest point: small (≤250 μm); medium (250–400 μm); or large (>400 μm). The cause may be primary or secondary, and VMT may be present or absent
Management and Treatment in Delhi NCR
How is a macular hole treated?
Treatment of the macular hole depends on stage and size of the macular hole. Your retina specialist will take this call depending on their observations, your symptoms and risk factors. They may choose to just observe and follow up for very early and very small macular holes as these may undergo spontaneous resolution.
The main treatment for later stage macular hole is a retina surgery called vitrectomy. In this surgery, the vitreous gel is removed along with any bits of tissue (membranes) which may be putting tension on your macula. The vitreous is replaced by a sterile gas which allows the macular hole to close.
What are the complications of vitrectomy for macular hole surgery?
Complications can arise in any surgery including retina surgery. Risks following a vitrectomy are:
- Infection
- Bleeding
- Increase in pressure (Glaucoma) or decrease in eye pressure
- Cataract- seen to progress in all retina surgeries
- Retinal detachment
- Macular hole not closing or reopening
It is important to remember that doctors weigh risk and benefit ratio before advising any surgery. If the Macular hole is progressive it may permanently lead to impaired or total loss of central fine vision if untreated.
After-surgery care & Prognosis
What happens after macular hole surgery?
After the surgery, you will be prescribed some eye drops and will have to maintain a face-down position for 7-10 days. There are some other precautions you may also have to follow which our retina specialists will explain to you such as air travel is restricted till the gas gets fully absorbed. The initial period after surgery is crucial for healing and we recommend all precautions are followed properly.
The gas helps to close the macular hole and slowly gets absorbed on its own over 6-8 weeks. It may take a few months for your eyes to stabilize and vision to improve after macular hole surgery.
Is there any special diet to follow during recovery from macular hole surgery?
No, there is no special diet you need to follow from an ophthalmology point of view. Patients are encouraged to maintain a face down position as much as possible- which means you are not very mobile. Patients find it easier to eat lighter meals as they can’t walk around much. If another doctor has recommended a diet, there is no restriction from our end. You must continue to take all your medication which your physician or other doctors may have prescribed.
When can I start working after macular hole surgery?
If you have had a vitrectomy with gas or oil placed inside your eye, you must maintain certain head positions most of the day. Your vision may also take some time to recover. These things may hinder your work for a few weeks.
How to maintain head positions after retina surgery watch now
What can I expect if I have a macular hole?
The success rate for minimally invasive vitrectomy surgery is excellent - but success depends on a lot of factors such as the stage of the condition, how recent it is and other risk factors. The surgery for macular hole is most successful when the hole is smaller and more recent. You may regain most or some of your lost vision.
While a lot of patients regain eyesight to different extent, as with all retina surgeries, a successful anatomical repositioning and reattachment doesn’t always mean full functional return of vision as before you developed the retina problem.
What is the prognosis for macular hole?
The prognosis is good if the macular hole is small and you get treatment early.
Without treatment or with late treatment you may lose much of your central vision. However, peripheral vision remains intact usually if there are no other associated retina problems.
Prevention
How can macular holes be prevented?
There is no definite way to prevent macular hole formation. If you do have any risk factors, be aware of the symptoms and if you get blurry vision, waviness or a black spot, consult a retina specialist as soon as you can.
This might help to diagnose and treat the condition at an early stage and prevent further complications. A macular hole which is small and fresh is associated with better visual improvement after surgery as compared to a large and long-standing one. Regular eye check-ups are also important to ensure that your eyes are healthy and do not have any eye disease.
Is treatment for macular hole available at Shroff Eye Centre?
Yes, treatment for macular hole i.e. vitrectomy and retina surgery is available at Shroff Eye Centre. As a tertiary referral eye centre with one of the best surgical retina teams in India, we regularly treat macular holes. Our award-winning retina team handles complex retina cases and are known for their technical skill with advanced equipment as well as their patient-first approach. To consult with our retina experts, please call us to book your appointment.
FAQs
Do all macular holes need surgery?
No. Very early and small holes may be observed because some close spontaneously. Your retina specialist will advise based on stage, size and symptoms.
What is vitrectomy and why is gas used?
Vitrectomy removes vitreous gel and tractional membranes; a sterile gas bubble then supports the macula to help the hole close.
How long do I need to stay face-down?
Typically 7–10 days, as instructed by your surgeon. This positioning helps the gas bubble seal the hole.
When can I fly?
Avoid air travel until the intraocular gas is fully absorbed (often 6–8 weeks). Your retina specialist will confirm when it’s safe.
Will my central vision fully recover?
Many patients regain some or most central vision, especially when surgery is done early. However, full pre-disease vision may not return.
Retina Patient Testimonials
See the Difference
Why Shroff Eye Centre?
1
Excellence
in Eyecare since 1914
2
Award winning
Eye specialists
3
Empathetic
Personalised patient care
4
Advanced care
1 lac happy eyes / year
5
Ethical
Patient-first approach
Patient Reviews
Great experience from the reception till departure. Dr. Cyrus is a great clinician and retina expert, thorough and reassuring. Indeed an authority in the subject. Thanks.
I had an excellent experience with Dr. Gagan Bhatia retina specialist. From the moment I walked in, the staff was warm and professional. Dr. Gagan Bhatia took the time to explain my condition in detail, answered all my questions patiently, and made sure I felt at ease throughout the process. The treatment was smooth, and I noticed a clear improvement in my vision. I highly recommend anyone with retina issues to visit them — truly an expert in the field.
I had a wonderful experience with Dr. Gagan Bhatia. He is not only highly skilled but also extremely patient and understanding. He took the time to explain my condition in detail, answered all my questions, and made me feel completely at ease throughout the treatment process. His expertise as a retina specialist is evident, and I felt confident and well cared for at every step. The staff was also very supportive, and the clinic was well-organized. I truly appreciate his professionalism and compassion and would highly recommend Dr. Gagan Bhatia to anyone seeking expert eye care.
I had a retina surgery and developed a glaucoma and then cataract , as with the young age it’s too dark time to go thru , but then some how I got a reference of DR. JASLEEN from Dr.Shroff centre kaushambi and got operated cataract on one of my eye . I should address here , that she is such a great expertise ,to me as a patient she was so polite to attend calls whenever I call her due to sudden phobia of eye treatments . Dr .jasleeen is most amazing and wonderful doctor . Still my routine check up is continuing with her . She is such a sweet as a person and as professional . And yes outcome of surgery is amazing and superb .
Macular-hole Treatment Near You
Kailash Colony
A-9, Lala Lajpat Rai Rd, Block A, Kailash Colony, Greater Kailash, New Delhi, Delhi 110048
South Delhi areas- Greater kailash, Lajpat nagar, Cr park, Defence colony, Niti bagh, Saket, Noida
GET DIRECTIONS
Connaught Place
Building (1st floor, 105, Surya Kiran, 19, KG Marg, New Delhi, Delhi 110001
Central Delhi- serving Karol bagh, Rajender Nagar, Civil lines
GET DIRECTIONS
Gurgaon
110 Bestech Chambers Radisson Suites, Block B, Sector 27, Gurugram, Haryana 122009
Haryana- Golf course road, Cyber city, Rewari, Sohna, Faridabad
GET DIRECTIONS
Ghaziabad
509, KM Trade Tower, adjacent to Radisson Blu, Sector 14, Kaushambi, Ghaziabad, Uttar Pradesh 201010
GET DIRECTIONS
Uttar Pradesh- Greater Noida, Ghaziabad, Merut, Bulandshahr, Hapur
References
- Majumdar S, Tripathy K. Macular Hole. [Updated 2023 Aug 25]. In: StatPearls [Internet]. Treasure Island (FL): StatPearls Publishing; 2025 Jan-. Available from: https://www.ncbi.nlm.nih.gov/books/NBK559200/
- Gass JD. Idiopathic senile macular hole. Its early stages and pathogenesis. Arch Ophthalmol. 1988 May;106(5):629-39. doi: 10.1001/archopht.1988.01060130683026. PMID: 3358729.
- Duker JS, Kaiser PK, Binder S, de Smet MD, Gaudric A, Reichel E, Sadda SR, Sebag J, Spaide RF, Stalmans P. The International Vitreomacular Traction Study Group classification of vitreomacular adhesion, traction, and macular hole. Ophthalmology. 2013 Dec;120(12):2611-2619. doi: 10.1016/j.ophtha.2013.07.042. Epub 2013 Sep 17. PMID: 24053995.
- Reviewed by Dr. Minal Sharma
Retina Specialist, Shroff Eye Centre Delhi
Updated: October 2025
Disclaimer
This is not medical advice. Your ophthalmologist will help you decide which procedure and lens is best suited for your eyes. Every patient and eye is different and thus the experience for every patient is variable.
All product and company names are trademarks or registered trademarks of their respective holders. Use of them does not imply any affiliation or endorsement by them.

By being on the website, your personal data is being processed for communication with you and providing services. We use cookies to collect and analyse information on site performance, usage, enhancement of customer usability and improvising the website. We have put in place terms of use,
By clicking on accept you agree to all the policies mentioned above. You can read more about them by clicking on read more and accept them individually.






 Call us
Call us Email us
Email us







